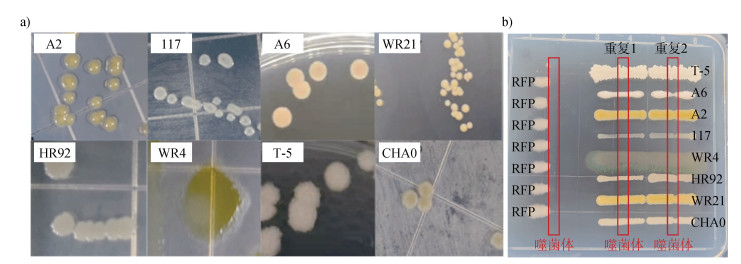

当前集约化农业快速发展,过量施用化肥、农药以及单一连作经济作物导致土壤生物障碍频发[1],严重威胁农产品安全供给。以茄科劳尔氏菌(Ralstonia solanacearum,简称青枯菌)引起的土壤青枯菌生物障碍为例,在我国乃至世界广泛存在,能够侵害两百多种植物包括番茄、马铃薯、烟草、花生等重要的粮食和经济作物[2],制约了农业的可持续发展。传统的化学防治,如农药杀菌剂或土壤熏蒸,短期内见效快但容易诱导病原菌产生耐药性,且因其广谱的杀菌作用,对土著微生物区系有破坏压制的风险[3],亟需绿色生态、精准高效消减土壤生物障碍的策略。
噬菌体是专性侵染细菌的病毒,噬菌体通过靶定宿主特异性受体,对目标病原菌进行精准裂解。当前噬菌体被广泛用于土壤生物障碍的消减[4-5],研究发现,土壤中施用噬菌体能有效降低病原青枯菌的种群数量,并且显著降低植物发病率[6]。但由于单一噬菌体宿主范围窄、病原菌的抗性进化等原因,在实际应用中对病原菌的消减效果不稳定[7],亟需建立提升噬菌体消减土壤生物障碍的技术体系。
植物根际定殖了大量的有益微生物,这些有益微生物可通过分泌抗生素、生长素、铁载体等功能物质,提高根际免疫力并促进作物生长[8-9],降低土壤生物障碍的发生。在病原菌入侵植物根际后,一些土著细菌与病原菌的资源利用特征相似,这些土著细菌通过与病原菌竞争根际土壤中有限的资源,抑制病原菌的增殖[10],将其定义为营养竞争型有益菌。另一部分土著细菌通过分泌抑制病原菌生长的次级代谢物,来抵制病原菌的定殖[11-12],将其定义为拮抗竞争型有益菌。在农业生产中,营养竞争型和拮抗竞争型有益菌均被广泛使用,但土壤环境复杂多变,有益菌的生防效果受到温度、湿度、养分等多种环境因素影响,使得单一有益菌的消减效果不稳定。
前期研究表明,噬菌体联合有益菌解淀粉芽孢杆菌能够增强消减土壤青枯菌生物障碍的效果[13],二者联用产生协同效应。但是否所有的有益菌与噬菌体组合均存在协同效应,低浓度有益菌与噬菌体组合是否会影响协同效应尚不清楚。为此,本研究拟以土壤青枯菌生物障碍为研究对象,通过不同类型(营养竞争型和拮抗竞争型)有益菌与噬菌体组合,评估二者的协同效果及接种浓度对协同效果的影响。进一步基于实验进化学探究了噬菌体-有益菌协同消减土壤青枯菌生物障碍的潜在机制。
1 材料与方法 1.1 供试材料 1.1.1 供试菌株病原菌:强致病力青枯菌QL-Rs1115[14],分离自南京麒麟镇发病番茄根际,其红色荧光蛋白标记菌株RFP为本研究的模式病原菌(表 1)。噬菌体:分离自发病番茄根际的病原青枯菌的专性噬菌体NN-P42[15](表 1)。有益菌为实验室保存的8株有益菌,分别为营养竞争型有益菌:皮氏罗尔斯顿菌Ralstonia pickettii QL-A6、QL-117、QL-A2和Chryseobacterium daecheongense WR21以及拮抗竞争型有益菌:解淀粉芽孢杆菌Bacillus amyloliquefaciens T-5[13]、荧光假单胞菌Pseudomonas fluorescens CHA0[9]、球形赖氨酸芽孢杆菌Lysinibacillus sphaericus HR92[16]、Flavobacterium johnsoniae WR4[16](表 1),均对青枯菌具有较强的抑制效果。8株有益菌的菌落形态如图 1a所示。
|
|
表 1 有益菌菌种信息 Table 1 Probiotics strain information |
|
注:A2为皮氏罗尔斯顿菌,117为皮氏罗尔斯顿菌,A6为皮氏罗尔斯顿菌,WR21为金黄杆菌,HR92为球形赖氨酸芽孢杆菌,WR4为约氏黄杆菌,T-5为解淀粉芽孢杆菌,CHA0为荧光假单胞菌,RFP为茄科劳尔氏菌。图b中红色框表示噬菌体悬液形成的一条直线,若菌株生长受到影响则表示能侵染,反之不能侵染。下同。 Note: A2 is Ralstonia pickettii, 117 is Ralstonia pickettii, A6 is Ralstonia pickettii, WR21 is Chryseobacterium daecheongense, HR92 is Lysinibacillus sphaericus, WR4 is Flavobacterium johnsoniae, T-5 is Bacillus amyloliquefaciens, CHA0 is Pseudomonas fluorescens, RFP is Ralstonia solanacearum. The red box in panel b indicates a straight line formed by the phage suspension. If the growth of the bacterial strain is inhibited, it means the phage can infect the strain; if there is no inhibition, the phage cannot infect it. The same as below. 图 1 8株有益菌菌落形态(a)及噬菌体对该8株有益菌的感染能力(b) Fig. 1 The colonial morphology of eight probiotic strains (a) and the detection of phage infectivity to these strains (b) |
营养琼脂培养基(NA):葡萄糖10 g·L–1,蛋白胨5 g·L–1,牛肉膏3 g·L–1,酵母粉0.5 g·L–1,添加1%琼脂制备半固体培养基,2%琼脂制备固体培养基。
青枯菌选择性培养基(SMSA):在NA培养基的基础上,加入结晶紫50 mg·L–1、多黏菌素100 mg·L–1、杆菌肽20 mg·L–1、氯霉素5 mg·L–1、放线菌酮50 mg·L–1、青霉素0.5 mg·L–1[17]。
胰酪大豆胨液体培养基(TSB):胰蛋白胨15 g·L–1,大豆蛋白胨5 g·L–1,氯化钠5 g·L–1。
胰酪大豆胨琼脂培养基(TSA):TSB培养基加1.5%琼脂粉。
基础无机盐培养基(OS):磷酸氢二钠7.01 g·L–1,磷酸二氢钾6.8 g·L–1,七水硫酸镁1.1 g·L–1,硫酸铵1.2 g·L–1,七水氯化钙88 mg·L–1,七水硫酸亚铁7 mg·L–1,四水钼酸铵0.2 mg·L–1,EDTA(乙二胺四乙酸)-钠2.5 mg·L–1,七水硫酸锌1.11 g·L–1,六水硫酸锰1.54 mg·L–1,五水硫酸铜0.39 mg·L–1,六水硝酸钴0.25 mg·L–1,十水硼酸钠0.18 mg·L–1,六水氯化镍1.3 mg·L–1。
1.2 方法 1.2.1 噬菌体特异性侵染评价试验本试验采用的青枯菌专性噬菌体NN-P42,利用划线法测定其对8株供试有益菌的侵染能力。具体方法:在平板上用噬菌体悬液淋一条直线,待噬菌体直线风干后,再利用无菌枪头蘸取细菌悬液,在噬菌体直线上方垂直划过,培养一段时间后,若细菌经过噬菌体的位置出现生长受到明显抑制的现象(菌株生长线会发生断裂),说明噬菌体能够侵染该细菌,反之不能侵染[18]。
1.2.2 供试菌悬液制备方法青枯菌RFP悬液制备:挑取青枯菌RFP单菌落转接至NA培养基中,30 ℃、170 r·min–1培养12 h,获得指数增长期的青枯菌。
噬菌体NN-P42悬液制备:将专性噬菌体NN-P42接种至指数增长期青枯菌悬液中,30 ℃、170 r·min–1培养12 h,4 ℃、10 000×g离心10 min,0.22 µm无菌滤膜过滤除菌,得到噬菌体的悬液。
有益菌悬液制备:挑取8株有益菌单菌落转接至NA培养基中,30 ℃、170 r·min–1培养12 h,获得指数增长期的有益菌。
1.2.3 噬菌体-有益菌协同抑菌的室内效果评估试验为探究8株有益菌与噬菌体是否存在协同效应,每株有益菌设置4个处理:1)仅接种青枯菌,2)接种青枯菌和噬菌体,3)接种青枯菌和有益菌,4)接种青枯菌、噬菌体和有益菌。采用96孔板体系,按200 μL总体系接种液体NA培养基,2 μL 1010 CFU·mL–1的青枯菌悬液、2μL 107 CFU·mL–1的有益菌悬液、2μL 107 PFU·mL–1的噬菌体悬液。30 ℃,170 r·min–1培养96 h,利用酶标仪(SpectraMax M5,Molecular Devices,Sunnyvale,加拿大)测定红色荧光值(激发光:587 nm,发射光:610 nm)来表征共培养体系中青枯菌的生长情况。
1.2.4 噬菌体-有益菌协同消减土壤青枯菌生物障碍的盆栽效果评估试验利用盆栽体系探究噬菌体-有益菌协同消减土壤青枯菌生物障碍的效果。选取三叶期且长势一致的番茄幼苗移栽至6孔盘,每孔装有200 g栽培专用基质土(江苏兴农基质科技有限公司)。番茄苗移栽后一周接种有益菌,接种有益菌一周后接种病原青枯菌,3 d后接种噬菌体[12]。接种浓度为青枯菌终浓度106 CFU·g–1基质、噬菌体终浓度105 PFU·g–1基质、有益菌终浓度105 CFU·g–1基质。对8株有益菌分别设置4个处理:1)仅接种青枯菌,2)接种青枯菌和噬菌体,3)接种青枯菌和有益菌,4)接种青枯菌、噬菌体和有益菌。每个处理4个重复,每个重复6株番茄苗。盆栽试验结束时统计各处理青枯病的发病等级(病情植株分级为0~4,0为无枯萎症状,1为1%~25%叶面积枯萎,2为26%~50%叶面积枯萎,3为51%~75%叶面积枯萎,4为76%~100%叶面积枯萎)。病情指数(%)= [∑(各级病株数×相应病情等级)/(调查总株数×最高病情等级)]×100[19]。
1.2.5 不同接种浓度对噬菌体-有益菌协同消减土壤青枯菌生物障碍效果的影响试验为探究不同接种浓度对噬菌体-有益菌协同消减土壤青枯菌生物障碍效果的影响,基于盆栽消减效果,分别选择一株营养竞争型有益菌和一株拮抗竞争型有益菌,通过上述室内孔板和盆栽试验体系探究浓度对协同效果的影响。孔板试验中,分别设置1)青枯菌初始接种浓度为104 CFU·mL–1、108 CFU·mL–1,噬菌体初始接种浓度为105 PFU·mL–1,有益菌初始接种浓度为105 CFU·mL–1;2)青枯菌初始接种浓度为108 CFU·mL–1,噬菌体初始接种浓度为104 PFU·mL–1、108 PFU·mL–1,有益菌初始接种浓度为105 CFU·mL–1;3)青枯菌初始接种浓度为108 CFU·mL–1,噬菌体初始接种浓度为105 PFU·mL–1,有益菌初始接种浓度分别为104 CFU·mL–1、108 CFU·mL–1。每个处理设置4个重复。通过测定共培养体系中的荧光值表征病原菌在不同处理中的生长情况,通过与对照(仅接种青枯菌)处理相比,计算有益菌-噬菌体协同的抑菌率。
利用盆栽试验中探究不同浓度有益菌与噬菌体组合对协同消减土壤青枯菌生物障碍的影响。其中有益菌浓度分别为0、104、105、106、107 CFU·g–1基质,噬菌体与青枯菌接种浓度同1.2.4。青枯菌、噬菌体和有益菌的接种方式同1.2.4。盆栽试验过程中统计青枯病的发病等级,25 d后盆栽试验结束。根据青枯病病情指数评价不同有益菌接种浓度对噬菌体-有益菌协同消减效果的影响。采集根际土壤,利用梯度稀释涂布法检测根际青枯菌的数量。
根际青枯菌数量测定:称取根际土3 g,加27 mL无菌水放置在30 ℃、170 r·min–1摇床中振荡2 h,吸取浊液梯度稀释后在SMSA选择性培养基上进行涂布,培养48 h后,统计各平板菌落数量,通过稀释倍数计算得到根际病原青枯菌数量。
1.2.6 噬菌体与有益菌组合对病原青枯菌的影响试验以上述营养竞争型有益菌WR21和拮抗竞争型有益菌T-5与噬菌体组合为例,从1.2.3室内孔板试验中随机选取培养48 h后不同处理(3个重复)的培养物,用选择性培养基SMSA筛选进化后的青枯菌。每个重复随机挑取2个青枯菌,每个处理各6个青枯菌。针对与营养竞争型有益菌-噬菌体共进化的青枯菌菌株,测定其对文献报道的番茄根系分泌物48种单一碳源的利用谱[9];针对与拮抗竞争型有益菌-噬菌体共进化的青枯菌,测定其对有益菌T-5产生的抗生物质的敏感性[12]。
碳源利用谱的测定:将NA培养基上活化的24个进化后青枯菌转接至TSA固体培养基上划线,30 ℃连续培养24 h,挑取单菌落转接至1/10 TSB液体培养基,培养24 h,调节OD600 = 0.5。在96孔板中每孔加入180 μL OS无机盐基础培养基和单一的碳源母液20 μL(终浓度为10 mmol·L–1)。每孔接种2μL菌悬液,置于30 ℃、170 r·min–1连续培养48 h,利用酶标仪测定OD600值,判定菌株在单一碳源条件下的生长情况。OD600 > 0.05则认为该菌株能够利用这种碳源,反之不能利用。统计进化后的青枯菌能够利用的48种单一碳源的总数,即为该菌株的碳源利用谱。
拮抗物质敏感性测定:收集拮抗竞争型有益菌T-5发酵液(37 ℃、170 r·min–1振荡培养36 h)。2 μL对数生长期进化后的青枯菌菌悬液(24个)分别接种至193 μL NA液体培养基中(96孔板体系),接种5 μL T-5发酵液,以5 μL NA液体培养基作为对照,30 ℃、170 r·min–1培养24 h后测定OD600。青枯菌敏感性=OD600 T5/OD600 CK×100%(OD600 CK:对照的生长量,OD600 T5:加有益菌发酵液的生长量)。
1.3 数据处理试验数据处理使用SPSS Statistics 22进行统计分析,两组数据的差异分析采用Wilcoxon秩和检验,多组数据差异分析采用单因素方差分析(Turkey’s HSD),采用R语言作图。
2 结果 2.1 噬菌体-有益菌组合对病原青枯菌生长的影响检测供试噬菌体NN-P42对8株有益菌的侵染能力,结果发现该噬菌体能够特异性侵染病原青枯菌RFP,而对8株有益菌的生长不产生影响,表明这8株有益菌均不会被噬菌体NN-P42侵染(图 1b)。进一步探究噬菌体与8株有益菌单独或组合对病原青枯菌生长的影响。如图 2所示,与单独接种有益菌的处理相比,营养竞争型有益菌117、A2、A6、WR21与噬菌体组合后,抑菌效果均显著提高(P<0.001),呈现协同效应。而在拮抗竞争型有益菌中,4株有益菌呈现出不同程度的抑菌效果,其中HR92与噬菌体的协同抑菌效果最为显著(P<0.01),T-5与噬菌体协同后抑菌效果同样存在显著差异(P<0.05),而WR4和噬菌体组合后,并未呈现协同效应。

|
注:同一菌株比较有无添加噬菌体的效果,显著性*P < 0.05,**P < 0.01,***P < 0.001,ns表示无显著差异。下同。 Note: The effects of phage addition on the same bacterial strain were compared. Statistical significance is denoted as follows: *P < 0.05, **P < 0.01, ***P < 0.001, ns indicates no significant difference. The same as below. 图 2 不同噬菌体-有益菌组合对病原青枯菌生长的影响(a.营养竞争型有益菌,b.拮抗竞争型有益菌) Fig. 2 Effects of different phage-probiotics combinations on growth of Ralstonia solanacearum (a. resource competition probiotics, b. antagonistic competition probiotics) |
与仅施用噬菌体相比,有益菌117、A2、A6、WR21、HR92、T-5、WR4在与噬菌体组合后抑菌效果显著提升(P<0.05),病原菌增长分别降低58.78%、76.25%、76.28%、75.06%、56.87%、70.92%、77.93%,而CHA0与噬菌体协同后,抑菌效果反而不如单独施用噬菌体。
上述结果表明,噬菌体和有益菌组合后会产生一定的协同效应,不同组合协同效应的强弱存在差异,且并非所有的有益菌与噬菌体组合均存在协同效应。
2.2 噬菌体-有益菌组合对土壤青枯菌生物障碍发生的影响噬菌体-有益菌协同处理可显著降低番茄青枯病的病情指数(图 3),其中,营养竞争型有益菌117、A2、A6、WR21和噬菌体组合后,与单独施用有益菌相比,病情指数分别降低54.57%(P<0.001)、57.32%(P<0.05)、46.29%(P<0.05)、39.51%(P<0.05),并且病情指数均低于单独施用噬菌体。在拮抗竞争型有益菌CHA0、HR92、T-5、WR4和噬菌体组合后,与单独施用有益菌相比,病情指数均有不同程度的降低,其中T-5效果最显著,病情指数降低43.13%(P<0.05)。上述结果进一步表明,噬菌体-有益菌的协同效应并非普遍现象。

|
图 3 不同噬菌体-有益菌组合对青枯病病情指数的影响(a.营养竞争型有益菌,b.拮抗竞争型有益菌) Fig. 3 Effects of different phage-probiotics combinations on bacterial wilt disease severity (a. resource competition probiotics, b. antagonistic competition probiotics) |
为进一步探究不同接种浓度对噬菌体-有益菌协同效应的影响,基于上述盆栽试验,分别选择了组合抑制病情指数效果最好的一株营养竞争型有益菌WR21和一株拮抗竞争型有益菌T-5与噬菌体NN-P42组合,探究初始接种浓度对协同效应的影响。
如图 4a所示,在青枯菌初始接种浓度由104 CFU·mL–1增加为108 CFU·mL–1时,WR21与噬菌体组合协同效应降低37.53%(P < 0.05),T-5与噬菌体组合协同效应没有显著变化。当噬菌体初始接种浓度由104 PFU-mL–1增加为108 PFU·mL–1时,WR21、T-5与噬菌体的组合分别抑制病原菌生长达11.73%(P < 0.05)和30.03%(P < 0.05)(图 4b)。当改变有益菌浓度时,如图 4c所示,WR21、T-5与噬菌体组合抑制病原菌生长的能力随着有益菌浓度的增加而分别显著增加37.69%(P < 0.05)和33.52%(P < 0.05)。

|
注:同一组合比较不同接种浓度的效果,显著性**P < 0.01,***P < 0.001,ns表示无显著差异。WR21+P和T-5+P:噬菌体和有益菌组合处理。 Note: The effects of initial inoculation concentration on the same combination were compared. Statistical significance is denoted as follows: **P < 0.01, ***P < 0.001, ns indicates no significant difference. WR21+P and T-5+P: probiotic and phage combination treatment. 图 4 初始接种浓度对噬菌体-有益菌协同的影响(a.不同病原菌浓度,b.不同噬菌体浓度,c.不同有益菌浓度) Fig. 4 Effect of initial inoculation concentrations of pathogen, phage and probiotics on phage-probiotics combination (a. different concentrations of pathogen, b. different concentrations of phage, c. different concentrations of probiotics) |
上述结果表明,接种浓度会影响噬菌体-有益菌的协同效应,病原菌浓度在一定范围内变化时,WR21与噬菌体组合的协同效应仍能保持较高的抑菌率;随着噬菌体浓度增高时,WR21与噬菌体和T-5与噬菌体协同效应的整体趋势也会增强;而当有益菌浓度较高时,WR21与噬菌体和T-5与噬菌体的协同抑菌能力很强,而当有益菌浓度较低时,协同效应依然存在良好的抑菌效果。
2.4 不同有益菌接种浓度对噬菌体-有益菌协同消减效应的影响为进一步探究有益菌浓度对噬菌体-有益菌协同消减土壤青枯菌生物障碍的影响,检测了番茄青枯菌生物障碍发生情况和根际病原菌的数量。在有益菌接种浓度为104、105、106、107 CFU·g–1与噬菌体的组合中,如图 5所示,随着有益菌终浓度的增高,番茄盆栽的病情指数总体呈下降趋势,根际病原菌数量也呈减少趋势。

|
注:同一接种浓度比较有无添加噬菌体的效果,显著性*P < 0.05,**P < 0.01,***P < 0.001,ns表示无显著差异。 Note: The effects of phage addition on the same initial inoculation concentration were compared. Statistical significance is denoted as follows: *P < 0.05, **P < 0.01, ***P < 0.001, ns indicates no significant difference. 图 5 不同有益菌接种浓度对噬菌体-有益菌组合防控青枯病病情指数和根际病原菌数量的影响(a. 营养竞争型有益菌WR21与噬菌体组合的病情指数和b.根际病原菌数量;c.拮抗竞争型有益菌T-5与噬菌体组合的病情指数和d.根际病原菌数量) Fig. 5 Effects of different probiotic inoculation concentrations on the disease severity and the number of rhizosphere pathogens with phage-probiotics combinations (a. Disease severity and b. rhizosphere pathogen density with the resource-competitive probiotic WR21 and phage combination; c. Disease severity and d. rhizosphere pathogen density with the antagonistic competitive probiotic T-5 and phage combination) |
与仅施用有益菌相比,如图 5a和图 5b所示,WR21与噬菌体组合在有益菌接种浓度为107 CFU·g–1时病情指数下降39.51%(P < 0.01),根际病原菌数量在106 CFU·g–1降低23.7%(P < 0.01)。T-5与噬菌体组合在有益菌浓度为107 CFU·g–1时病情指数下降43.14%(P < 0.05)(图 5c),根际病原菌数量在106 CFU·g–1降低46.07%(P < 0.001)(图 5d)。值得一提的是,即使是在104 CFU·g–1浓度下,WR21、T-5与噬菌体的组合的消减效果均优于单独施用有益菌。
与仅施用噬菌体相比,随着营养竞争型有益菌WR21浓度的升高,盆栽病情指数和根际病原菌数量显著降低(P<0.05)(图 5a,图 5b),抑菌效果逐渐变强。图 5c和图 5d显示,T-5在104 CFU·g–1浓度时的组合的病情指数与仅施用噬菌体相比反而显著增高(P<0.05),在106 CFU·g–1、107 CFU·g–1浓度时病情指数显著降低(P<0.05),但根际病原菌数量随有益菌浓度的升高并未发生显著变化,抑菌效果也逐步稳定。上述结果表明,在有益菌高浓度下,噬菌体-有益菌的协同效应会得到加强,在有益菌低浓度下,噬菌体-有益菌仍然会存在良好的协同效应。
2.5 噬菌体-有益菌协同胁迫对青枯菌特性的影响为初步探究协同效应抑制青枯菌的潜在机制,分别选取上述营养竞争型有益菌WR21和拮抗竞争型有益菌T-5与噬菌体的组合,筛选不同处理胁迫下(共培养48 h)进化后的青枯菌。
通过青枯菌对48种根系分泌物资源的碳源利用谱来表征病原菌在营养竞争型有益菌-噬菌体协同效应下受到的影响。图 6a显示在施用噬菌体-有益菌组合时,与仅青枯菌单独进化的菌株相比,二者组合胁迫下进化的青枯菌能够利用的碳源数量下降87.9%(P < 0.05),与单独有益菌或噬菌体胁迫相比,分别降低81.7%(P < 0.05)、69.1%(P < 0.05)。上述结果表明,噬菌体-有益菌组合能够显著抑制病原菌可利用的碳源种类,说明二者协同可能会削弱病原菌的资源竞争能力。

|
注:不同字母代表在P ≤ 0.05的水平上有显著差异。 Note: Different letters indicate statistical significance at P ≤ 0.05 levels. 图 6 不同处理进化后的病原菌的碳源利用能力(a)和对T-5产生的抗生物质的敏感性(b) Fig. 6 Carbon source utilization ability of pathogens evolved under different treatments (a) and sensitivity to antibiotics produced by T-5 (b) |
通过测定病原菌对有益菌T-5产生的抗生物质的敏感性来反映青枯菌在拮抗型有益菌-噬菌体协同胁迫下受到的影响。如图 6b所示,青枯菌在噬菌体-有益菌协同胁迫下,对T-5产生的抗生物质的敏感性提高64.1%(P < 0.05),与单独T-5处理相比提高45.1%(P < 0.05)。试验结果表明,噬菌体-有益菌协同会显著提高青枯菌对有益菌产生的抗生物质的敏感性,从而减缓病原菌的生长。说明噬菌体-有益菌组合时能够大大增加病原菌的生长成本,使得病原菌在资源竞争和拮抗竞争中处于劣势,进而达到消减病原菌的作用。
3 讨论 3.1 噬菌体-有益菌组合提升土壤生物障碍消减的效果大量研究表明,根际微生物在消减土壤生物障碍的过程中发挥重要作用,一些功能微生物与噬菌体均能够不同程度减缓土壤生物障碍的发生[4,20],但单一措施消减效果受到多种因素影响且成本较高。本研究通过构建噬菌体-有益菌协同体系,评估了噬菌体-有益菌组合协同消减土壤青枯菌生物障碍的效果,初步探究协同效应的潜在机制。实验室前期发现营养竞争型有益菌Chryseobacterium daecheongense WR21对有机酸具有更强的趋化能力,且能够利用多种碳源,与青枯菌具有较强的碳源利用竞争能力[21];而拮抗竞争型有益菌Bacillus amyloliquefaciens T-5通过分泌Macrolactin A和Bacillaene两类抑菌物质[22]或产生挥发性有机物抑制病原青枯菌[23]。这两株菌作为营养竞争型和拮抗竞争型有益菌的典型代表,在与噬菌体组合后均表现出良好的协同效果。与对照相比,拮抗竞争型有益菌T-5和噬菌体组合后病情指数降低69.39%,营养竞争型有益菌WR21和噬菌体组合病情指数降低67.28%(图 3),这与王佳宁[24]等的研究结果类似,将噬菌体鸡尾酒联合生物有机肥消减土壤青枯菌生物障碍,发现二者联用后较仅施用生物有机肥的障碍发生降低了86.21%,且显著改变根际细菌群落结构和物种组成。
本研究发现,当病原菌数量在104~108 CFU·mL–1范围内变化时,噬菌体-有益菌T-5的协同抑菌效果未发生显著变化(图 4),表明噬菌体-有益菌协同效应仍能很好地应对病原菌数量变化,这也意味着噬菌体-有益菌协同可能在植株发病前期、中期、后期均能维持良好的消减效果。但研究也发现,有益菌的浓度也并非越高越好(图 5)。拮抗和营养竞争是微生物群落的主要驱动因素[22],菌株之间可能存在一定的竞争作用,当有益菌浓度过高时,协同效应反而会降低,如营养竞争型有益菌(WR21)、拮抗型有益菌(T-5)在浓度由106 CFU·g–1提升至107 CFU·g–1时,与噬菌体协同处理下的番茄盆栽病情指数和根际病原菌数量并未发生显著变化(图 5),说明在噬菌体的协助下,低浓度的有益菌可以实现稳定的消减效果,在实际生产应用过程中可利用噬菌体和有益菌协同来降低有益菌的发酵成本。
3.2 噬菌体-有益菌协同的潜在机制根际微生物对有限根系分泌物和生态位的争夺使得群落中竞争能力强的物种具有更强的竞争优势。而根际微生物对于根系分泌物和生态位的竞争主要来源于两部分,一是利用性竞争,即微生物对根际生态位和营养的竞争;二是干扰性竞争,即微生物通过分泌代谢产物干扰或抑制其余微生物。而前期研究结果[21]发现,WR21与青枯菌QL-Rs1115均能够利用番茄根系分泌物中的多种碳源,两者的生态位高度重叠,WR21通过与青枯菌QL-Rs1115竞争有限的营养物质来抑制病原菌的生长,进一步抑制或干扰青枯菌QL-Rs1115的生长,使得WR21在与病原青枯菌的营养竞争中占据优势地位[21]。除此之外,微生物还可通过其他策略增加资源的获取,如产生拮抗物质等。拮抗竞争型有益菌T-5能够分泌两种聚酮类拮抗物质,分别为Macrolactin A和Bacillaene[22]。其中,Macrolactin A通过抑制细胞壁的合成以及细胞分裂中的一个或多个过程而具有抑菌活性[25]。Bacillaene能够抑制原核生物蛋白质的合成[26],董月[27]从T-5的发酵液中分离纯化得到Bacillaene并证明其对青枯菌具有强烈的抑制作用。本研究发现噬菌体-有益菌协同能够增加青枯菌的生存成本,降低青枯菌的碳源利用能力,增加其对有益菌产生的拮抗物质的敏感性(图 6),这与前期研究结果[12,28]一致。根据生存-致病权衡[29],病原菌为了应对噬菌体胁迫,会将更多的资源分配至生长和繁殖,使得噬菌体抗性增强但竞争、毒性下降[10],有益菌(如WR21、T-5)则会快速占据有限的生态位,使其在与病原菌的竞争中占据优势。前期研究表明噬菌体侵染病原菌后裂解细菌,为有益菌创造了有利的生存空间,帮助土壤中的有益菌在根际定殖[5]。噬菌体和有益菌对病原菌的消减机制不同,二者的协同能够弥补单一措施的局限性,提高土壤生物障碍的消减效率和稳定性。
4 结论本研究探究了营养竞争型和拮抗竞争型两类有益菌与噬菌体组合对土壤青枯菌生物障碍的消减效果和潜在机制,发现与单独施用有益菌或噬菌体相比,营养竞争型有益菌WR21和拮抗竞争性有益菌T-5与噬菌体NN-P42组合后消减效果较为显著,其中WR21-噬菌体组合后能够显著降低青枯菌利用碳源的种类,而T-5-噬菌体组合后能够提高青枯菌对拮抗物质的敏感性,增加病原青枯菌的生存成本,削弱其竞争能力。研究结果为高效稳定的土壤生物障碍消减技术体系的建立提供了理论基础和技术支撑。
| [1] |
Lamichhane J R, Barbetti M J, Chilvers M I, et al. Exploiting root exudates to manage soil-borne disease complexes in a changing climate[J]. Trends in Microbiology, 2024, 32(1): 27-37. DOI:10.1016/j.tim.2023.07.011
(  0) 0) |
| [2] |
Jiang G F, Wei Z, Xu J, et al. Bacterial wilt in China: History, current status, and future perspectives[J]. Frontiers in Plant Science, 2017, 8: 1549. DOI:10.3389/fpls.2017.01549
(  0) 0) |
| [3] |
Chen Y L, Zhang Y H, Xu R S, et al. Effects of anaerobic soil disinfestation on antibiotics, human pathogenic bacteria, and their associated antibiotic resistance genes in soil[J]. Applied Soil Ecology, 2024, 195: 105266. DOI:10.1016/j.apsoil.2023.105266
(  0) 0) |
| [4] |
Wang X F, Tang Y K, Yue X F, et al. The role of rhizosphere phages in soil health[J]. FEMS Microbiology Ecology, 2024, 100(5): fiae052. DOI:10.1093/femsec/fiae052
(  0) 0) |
| [5] |
Wang X F, Wang S, Huang M C, et al. Phages enhance both phytopathogen density control and rhizosphere microbiome suppressiveness[J]. mBio, 2024, 15(6): e0301623. DOI:10.1128/mbio.03016-23
(  0) 0) |
| [6] |
Wang X F, Wei Z, Yang K M, et al. Phage combination therapies for bacterial wilt disease in tomato[J]. Nature Biotechnology, 2019, 37(12): 1513-1520. DOI:10.1038/s41587-019-0328-3
(  0) 0) |
| [7] |
Wang X F, Jiang G F, Wang S, et al. Constraining factors and enhancement strategies of phage therapy in controlling soil biological pollution (In Chinese)[J]. Acta Pedologica Sinica, 2023, 60(5): 1378-1388. DOI:10.11766/trxb202307110265 [王孝芳, 江高飞, 王硕, 等. 噬菌体靶向消减土壤生物污染的制约因素及提升策略[J]. 土壤学报, 2023, 60(5): 1378-1388.]
(  0) 0) |
| [8] |
Gu S H, Wei Z, Shao Z Y, et al. Competition for iron drives phytopathogen control by natural rhizosphere microbiomes[J]. Nature Microbiology, 2020, 5(8): 1002-1010. DOI:10.1038/s41564-020-0719-8
(  0) 0) |
| [9] |
Kong Y L, Qin H, Zhu C Q, et al. Research progress on the mechanism of soil microorganisms affecting soil health (In Chinese)[J]. Acta Pedologica Sinica, 2024, 61(2): 331-347. DOI:10.11766/trxb202301200448 [孔亚丽, 秦华, 朱春权, 等. 土壤微生物影响土壤健康的作用机制研究进展[J]. 土壤学报, 2024, 61(2): 331-347.]
(  0) 0) |
| [10] |
Wei Z, Yang T J, Friman V P, et al. Trophic network architecture of root-associated bacterial communities determines pathogen invasion and plant health[J]. Nature Communications, 2015, 6: 8413. DOI:10.1038/ncomms9413
(  0) 0) |
| [11] |
Hu J, Wei Z, Friman V P, et al. Probiotic diversity enhances rhizosphere microbiome function and plant disease suppression[J]. mBio, 2016, 7(6): e01790-e01716.
(  0) 0) |
| [12] |
Chen H, Tang H Y, Guo J H, et al. Main functions of root exudates and advances in analytical technology (In Chinese)[J]. Soils, 2023, 55(2): 225-233. [陈虹, 唐昊冶, 郭家欢, 等. 根系分泌物主要作用及解析技术进展[J]. 土壤, 2023, 55(2): 225-233.]
(  0) 0) |
| [13] |
Wang X F, Wei Z, Li M, et al. Parasites and competitors suppress bacterial pathogen synergistically due to evolutionary trade-offs[J]. Evolution, 2017, 71(3): 733-746. DOI:10.1111/evo.13143
(  0) 0) |
| [14] |
Tan S Y, Gu Y, Yang C L, et al. Bacillus amyloliquefaciens T-5 may prevent Ralstonia solanacearum infection through competitive exclusion[J]. Biology and Fertility of Soils, 2016, 52(3): 341-351. DOI:10.1007/s00374-015-1079-z
(  0) 0) |
| [15] |
Wang J N, Wang X F, Yang K M, et al. Phage selection drives resistance–virulence trade-offs in Ralstonia solanacearum plant-pathogenic bacterium irrespective of the growth temperature[J]. Evolution Letters, 2024, 8(2): 253-266. DOI:10.1093/evlett/qrad056
(  0) 0) |
| [16] |
Huang J F, Wei Z, Tan S Y, et al. The rhizosphere soil of diseased tomato plants as a source for novel microorganisms to control bacterial wilt[J]. Applied Soil Ecology, 2013, 72: 79-84. DOI:10.1016/j.apsoil.2013.05.017
(  0) 0) |
| [17] |
Elphinstone J G, Hennessy J, Wilson J K, et al. Sensitivity of different methods for the detection of Ralstonia solanacearum in potato tuber extracts[J]. EPPO Bulletin, 1996, 26(3/4): 663-678.
(  0) 0) |
| [18] |
Koskella B. Bacteria-phage interactions across time and space: Merging local adaptation and time-shift experiments to understand phage evolution[J]. The American Naturalist, 2014, 184(Suppl 1): S9-S21.
(  0) 0) |
| [19] |
Yang K M, Fu R X, Feng H C, et al. RIN enhances plant disease resistance via root exudate-mediated assembly of disease-suppressive rhizosphere microbiota[J]. Molecular Plant, 2023, 16(9): 1379-1395. DOI:10.1016/j.molp.2023.08.004
(  0) 0) |
| [20] |
Chepsergon J, Moleleki L N. Rhizosphere bacterial interactions and impact on plant health[J]. Current Opinion in Microbiology, 2023, 73: 102297. DOI:10.1016/j.mib.2023.102297
(  0) 0) |
| [21] |
Huang J F. Prevention and control of soil-borne bacterial wilt by antagonistic bacteria originating from the rhizosphere of diseased and healthy tomatoes[D]. Nanjing: Nanjing Agricultural University, 2014.[黄建凤. 源自发病与健康番茄根际的拮抗菌对土传青枯病的防控及机理研究[D]. 南京: 南京农业大学, 2014.]
(  0) 0) |
| [22] |
Yang C L, Dong Y, Friman V P, et al. Carbon resource richness shapes bacterial competitive interactions by alleviating growth-antibiosis trade-off[J]. Functional Ecology, 2019, 33(5): 868-875. DOI:10.1111/1365-2435.13292
(  0) 0) |
| [23] |
Raza W, Wang J C, Wu Y C, et al. Effects of volatile organic compounds produced by Bacillus amyloliquefaciens on the growth and virulence traits of tomato bacterial wilt pathogen Ralstonia solanacearum[J]. Applied Microbiology and Biotechnology, 2016, 100(17): 7639-7650. DOI:10.1007/s00253-016-7584-7
(  0) 0) |
| [24] |
Wang J N, Wang Y X, Hou R J, et al. Biocontrol of phage cocktail combined with bio-organic fertilizer on tomato bacterial wilt (In Chinese)[J]. Microbiology China, 2021, 48(9): 3194-3204. [王佳宁, 王玉鑫, 侯如娇, 等. 噬菌体鸡尾酒联合生物有机肥防控番茄青枯病的效果研究[J]. 微生物学通报, 2021, 48(9): 3194-3204.]
(  0) 0) |
| [25] |
Huang J F, Wei Z, Hu J, et al. Chryseobacterium nankingense sp. nov. WR21 effectively suppresses Ralstonia solanacearum growth via intensive root exudates competition[J]. BioControl, 2017, 62(4): 567-577. DOI:10.1007/s10526-017-9812-1
(  0) 0) |
| [26] |
Miao S, Liang J H, Xu Y, et al. Bacillaene, sharp objects consist in the arsenal of antibiotics produced by Bacillus[J]. Journal of Cellular Physiology, 2024, 239(8): e31228. DOI:10.1002/jcp.31228
(  0) 0) |
| [27] |
Dong Y. Competition between Bacillus amyloliquefaciens T-5 and Ralstonia solanacearum for tomato root exudates and its mechanism[D]. Nanjing: Nanjing Agricultural University, 2014.[董月. 解淀粉芽孢杆菌T-5与青枯菌对番茄根系分泌物的竞争及机理研究[D]. 南京: 南京农业大学, 2014.]
(  0) 0) |
| [28] |
Wang J N, Wang X F, Yang K M, et al. Phage selection drives resistance-virulence trade-offs in Ralstonia solanacearum plant-pathogenic bacterium irrespective of the growth temperature[J]. Evolution Letters, 2024, 8(2): 253-266. DOI:10.1093/evlett/qrad056
(  0) 0) |
| [29] |
Wei Z, Wang J N, Jiang G F, et al. Survival-virulence trade-off of soil-borne pathogenic bacteria (In Chinese)[J]. Acta Pedologica Sinica, 2022, 59(2): 324-333. DOI:10.11766/trxb202008310399 [韦中, 王佳宁, 江高飞, 等. 土传病原细菌的生存与致病权衡[J]. 土壤学报, 2022, 59(2): 324-333.]
(  0) 0) |
 2025, Vol. 62
2025, Vol. 62


